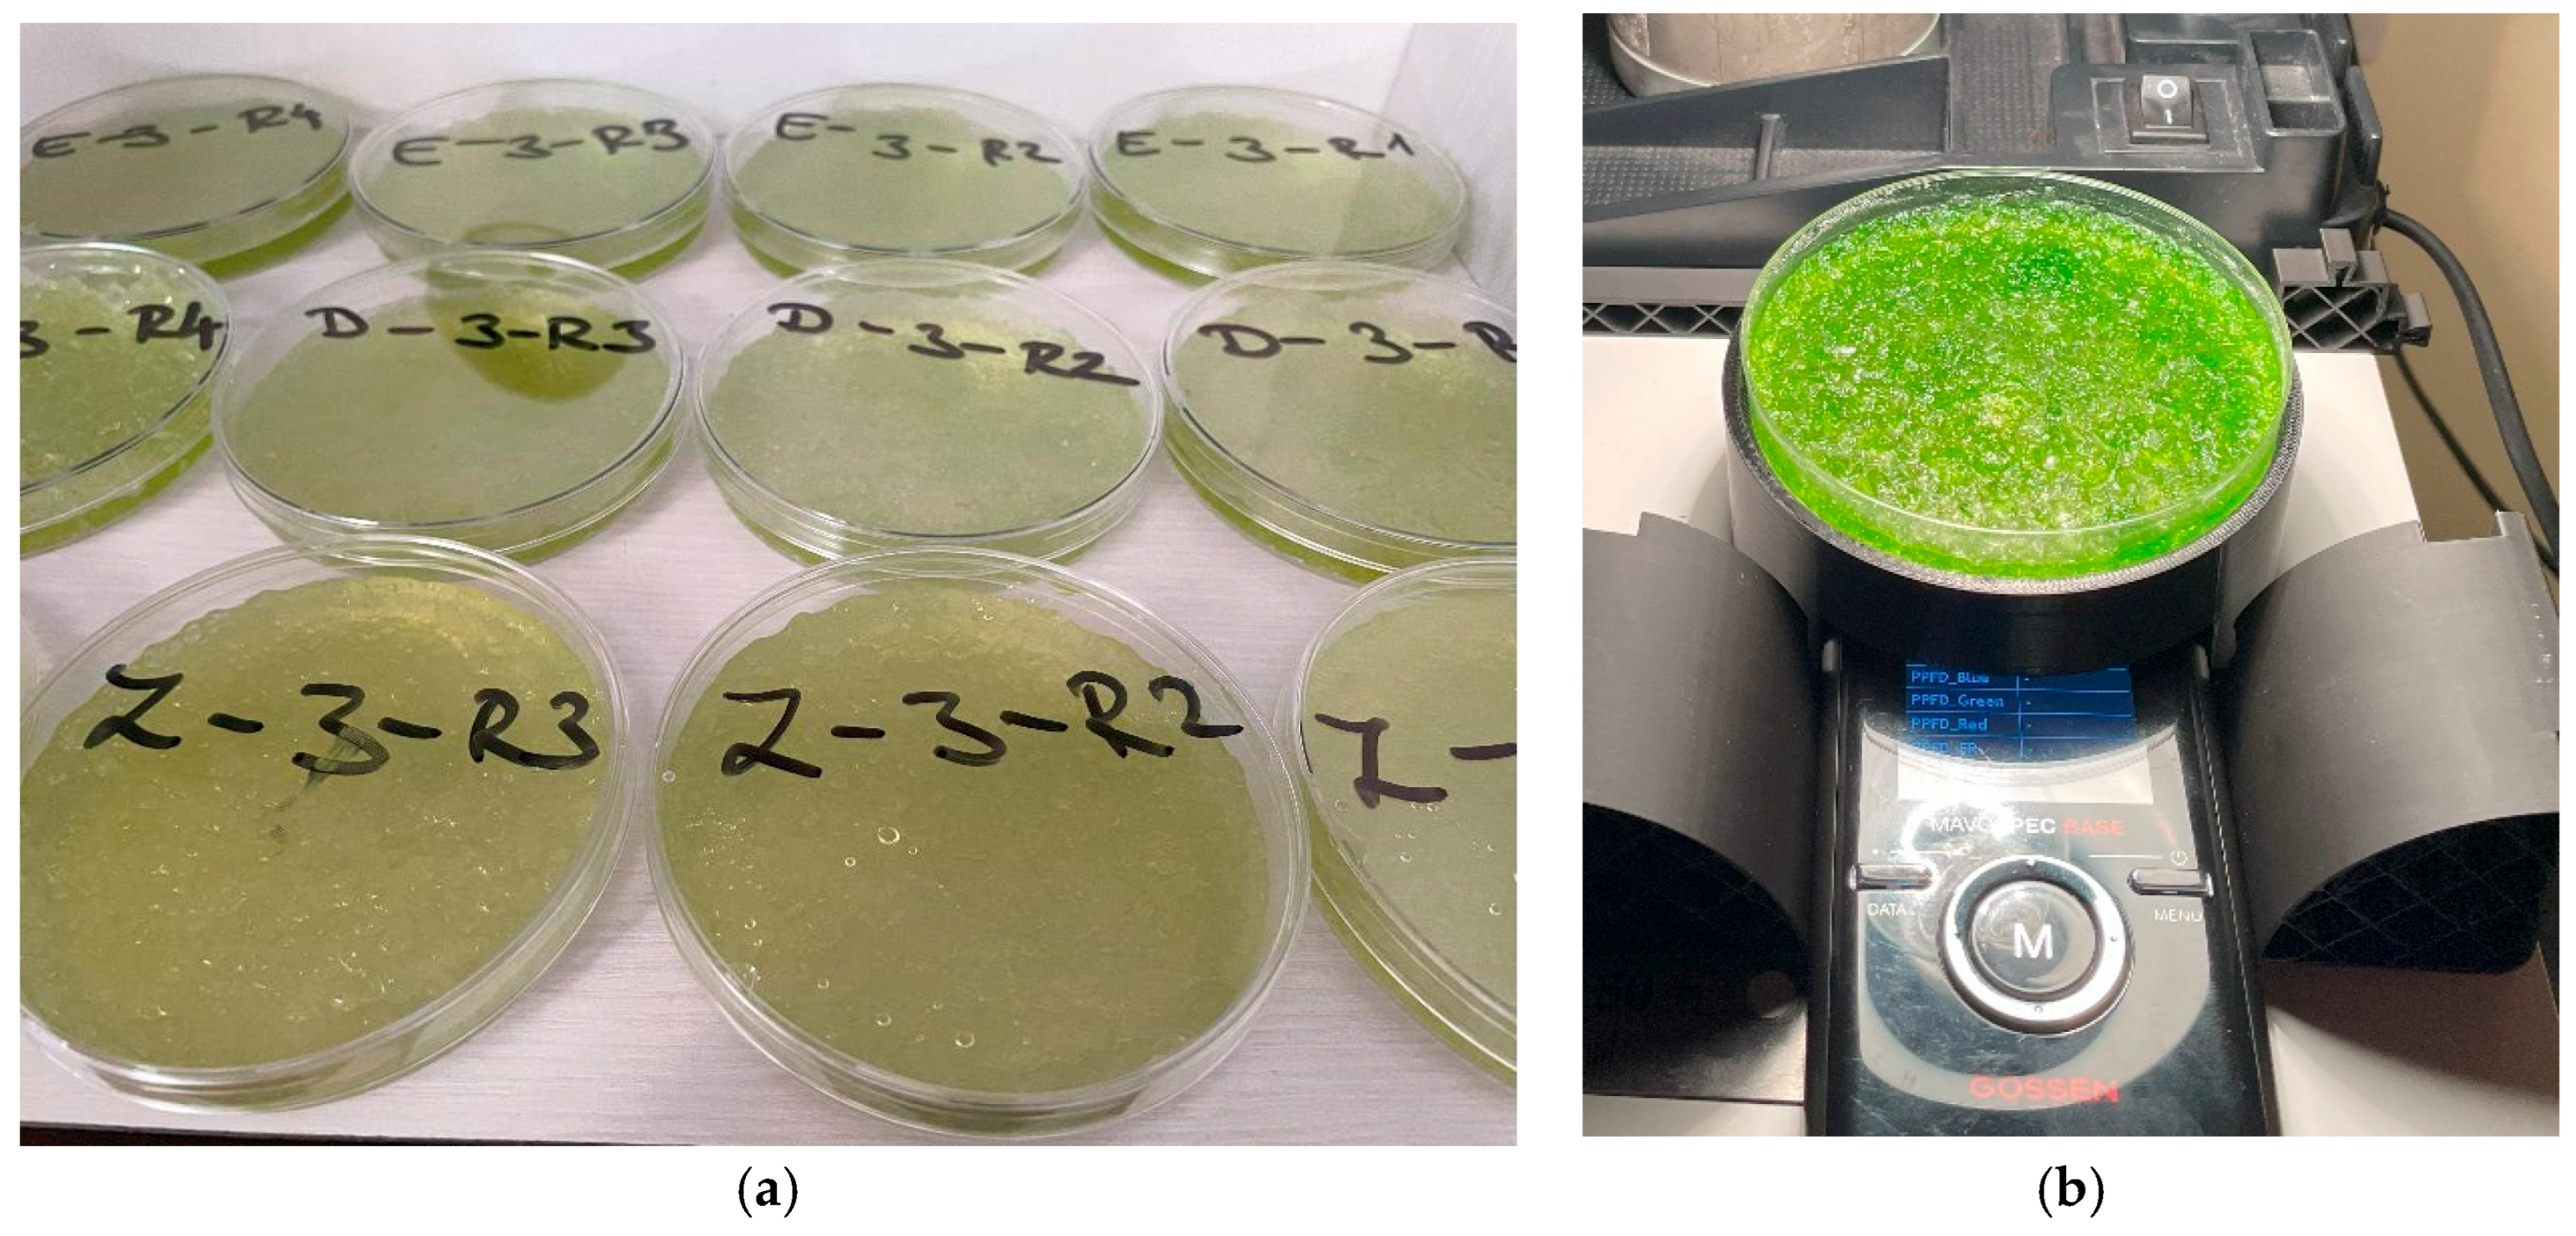
Plants 14 02962 g015

Figure 1.
Cross-sectional Integrated Absorbance by SAP within algal densities (averaged over weeks 2–7). Boxes show the median and interquartile range; whiskers extend to 1.5 × IQR; points are individual observations. Panels correspond to algal densities ((a): 22.8 × 103; (b): 228 × 103; (c): 2.228 × 106 cells/mL). Letters above boxes denote groups not significantly different at α = 0.05 based on Dunn–Bonferroni pairwise tests following a Kruskal–Wallis test conducted separately within each density.
Figure 1.
Cross-sectional Integrated Absorbance by SAP within algal densities (averaged over weeks 2–7). Boxes show the median and interquartile range; whiskers extend to 1.5 × IQR; points are individual observations. Panels correspond to algal densities ((a): 22.8 × 103; (b): 228 × 103; (c): 2.228 × 106 cells/mL). Letters above boxes denote groups not significantly different at α = 0.05 based on Dunn–Bonferroni pairwise tests following a Kruskal–Wallis test conducted separately within each density.
Figure 2.
Cross-sectional Chlorophyll Index by SAP within algal densities (averaged over weeks 2–7). Boxes show median and interquartile range; whiskers extend to 1.5 × IQR; points are individual observations. Panels correspond to algal densities ((a): 22.8 × 103; (b): 228 × 103; (c): 2.228 × 106 cells/mL). Letters above boxes denote groups not significantly different at α = 0.05 by Dunn–Bonferroni pairwise tests following a Kruskal–Wallis test run separately within each density.
Figure 2.
Cross-sectional Chlorophyll Index by SAP within algal densities (averaged over weeks 2–7). Boxes show median and interquartile range; whiskers extend to 1.5 × IQR; points are individual observations. Panels correspond to algal densities ((a): 22.8 × 103; (b): 228 × 103; (c): 2.228 × 106 cells/mL). Letters above boxes denote groups not significantly different at α = 0.05 by Dunn–Bonferroni pairwise tests following a Kruskal–Wallis test run separately within each density.
Figure 3.
Cross-sectional Blue/Red Ratio by SAP within algal densities (averaged over weeks 2–7). Boxes show the median and interquartile range; whiskers extend to 1.5 × IQR; points are individual observations. Panels correspond to algal densities ((a): 22.8 × 103; (b): 228 × 103; (c): 2.228 × 106 cells/mL). Letters above boxes denote groups not significantly different at α = 0.05 by Dunn–Bonferroni tests following density-specific Kruskal–Wallis analyses.
Figure 3.
Cross-sectional Blue/Red Ratio by SAP within algal densities (averaged over weeks 2–7). Boxes show the median and interquartile range; whiskers extend to 1.5 × IQR; points are individual observations. Panels correspond to algal densities ((a): 22.8 × 103; (b): 228 × 103; (c): 2.228 × 106 cells/mL). Letters above boxes denote groups not significantly different at α = 0.05 by Dunn–Bonferroni tests following density-specific Kruskal–Wallis analyses.
Figure 4.
Cross-sectional NDAI by SAP within algal densities (averaged over weeks 2–7). Boxes show the median and interquartile range; whiskers extend to 1.5 × IQR; points are individual observations. Panels correspond to algal densities ((a): 22.8 × 103; (b): 228 × 103; (c): 2.228 × 106 cells/mL). Letters above boxes denote groups not significantly different at α = 0.05 by Dunn–Bonferroni tests following density-specific Kruskal–Wallis analyses.
Figure 4.
Cross-sectional NDAI by SAP within algal densities (averaged over weeks 2–7). Boxes show the median and interquartile range; whiskers extend to 1.5 × IQR; points are individual observations. Panels correspond to algal densities ((a): 22.8 × 103; (b): 228 × 103; (c): 2.228 × 106 cells/mL). Letters above boxes denote groups not significantly different at α = 0.05 by Dunn–Bonferroni tests following density-specific Kruskal–Wallis analyses.
Figure 5.
Cross-sectional Photochemical Reflectance Index (PRI) by SAP within algal densities (averaged over weeks 2–7). Boxes show median and interquartile range; whiskers extend to 1.5 × IQR; points are individual observations. Panels correspond to algal densities ((a): 22.8 × 103; (b): 228 × 103; (c): 2.228 × 106 cells/mL). Letters above boxes denote groups not significantly different at α = 0.05 based on Dunn–Bonferroni pairwise tests following density-specific Kruskal–Wallis analyses.
Figure 5.
Cross-sectional Photochemical Reflectance Index (PRI) by SAP within algal densities (averaged over weeks 2–7). Boxes show median and interquartile range; whiskers extend to 1.5 × IQR; points are individual observations. Panels correspond to algal densities ((a): 22.8 × 103; (b): 228 × 103; (c): 2.228 × 106 cells/mL). Letters above boxes denote groups not significantly different at α = 0.05 based on Dunn–Bonferroni pairwise tests following density-specific Kruskal–Wallis analyses.
Figure 6.
Cross-sectional NPQI by SAP within algal densities (averaged over weeks 2–7). Boxes show median and interquartile range; whiskers extend to 1.5 × IQR; points are individual observations. Panels correspond to algal densities ((a): 22.8 × 103; (b): 228 × 103; (c): 2.228 × 106 cells/mL). Letters above boxes denote groups not significantly different at α = 0.05 by Dunn–Bonferroni pairwise tests following density-specific Kruskal–Wallis analyses.
Figure 6.
Cross-sectional NPQI by SAP within algal densities (averaged over weeks 2–7). Boxes show median and interquartile range; whiskers extend to 1.5 × IQR; points are individual observations. Panels correspond to algal densities ((a): 22.8 × 103; (b): 228 × 103; (c): 2.228 × 106 cells/mL). Letters above boxes denote groups not significantly different at α = 0.05 by Dunn–Bonferroni pairwise tests following density-specific Kruskal–Wallis analyses.
Figure 7.
Relative treatment effects for integrated absorbance over seven measurement weeks, by SAP treatment and algae density. Panels show nonparametric RTE trajectories (0 = below, 1 = above the pooled median) for Control, Aquaperla, Stockosorb, and Zeba, with line colour indicating algae concentration (22.8 × 103, 228 × 103, 2.228 × 106 cells/mL).
Figure 7.
Relative treatment effects for integrated absorbance over seven measurement weeks, by SAP treatment and algae density. Panels show nonparametric RTE trajectories (0 = below, 1 = above the pooled median) for Control, Aquaperla, Stockosorb, and Zeba, with line colour indicating algae concentration (22.8 × 103, 228 × 103, 2.228 × 106 cells/mL).
Figure 8.
Relative treatment effects for chlorophyll index over seven measurement weeks, by SAP treatment and algae density. Panels show nonparametric RTE trajectories (0 = below, 1 = above the pooled median) for Control, Aquaperla, Stockosorb, and Zeba, with line color indicating algae concentration (22.8 × 103, 228 × 103, 2.228 × 106 cells/mL).
Figure 8.
Relative treatment effects for chlorophyll index over seven measurement weeks, by SAP treatment and algae density. Panels show nonparametric RTE trajectories (0 = below, 1 = above the pooled median) for Control, Aquaperla, Stockosorb, and Zeba, with line color indicating algae concentration (22.8 × 103, 228 × 103, 2.228 × 106 cells/mL).
Figure 9.
Relative treatment effects for blue/red absorbance ratio over seven measurement weeks, by SAP treatment and algae density. Panels show nonparametric RTE trajectories (0 = below, 1 = above the pooled median) for Control, Aquaperla, Stockosorb, and Zeba, with line color indicating algae concentration (22.8 × 103, 228 × 103, 2.228 × 106 cells/mL).
Figure 9.
Relative treatment effects for blue/red absorbance ratio over seven measurement weeks, by SAP treatment and algae density. Panels show nonparametric RTE trajectories (0 = below, 1 = above the pooled median) for Control, Aquaperla, Stockosorb, and Zeba, with line color indicating algae concentration (22.8 × 103, 228 × 103, 2.228 × 106 cells/mL).
Figure 10.
Relative treatment effects for normalized difference algal index over seven measurement weeks, by SAP treatment and algae density. Panels show nonparametric RTE trajectories (0 = below, 1 = above the pooled median) for Control, Aquaperla, Stockosorb, and Zeba, with line color indicating algae concentration (22.8 × 103, 228 × 103, 2.228 × 106 cells/mL).
Figure 10.
Relative treatment effects for normalized difference algal index over seven measurement weeks, by SAP treatment and algae density. Panels show nonparametric RTE trajectories (0 = below, 1 = above the pooled median) for Control, Aquaperla, Stockosorb, and Zeba, with line color indicating algae concentration (22.8 × 103, 228 × 103, 2.228 × 106 cells/mL).
Figure 11.
Weekly Relative Treatment Effects (RTEs) for the Photochemical Reflectance Index (PRI) over seven measurement weeks, shown by SAP treatment (panels: Control, Aquaperla, Stockosorb, Zeba) and algae density (lines: 22.8 × 103, 228 × 103, 2.228 × 106 cells/mL). RTE (0–1) denotes the probability that observations from a group exceed the pooled distribution (0 = mostly below, 1 = mostly above the pooled median).
Figure 11.
Weekly Relative Treatment Effects (RTEs) for the Photochemical Reflectance Index (PRI) over seven measurement weeks, shown by SAP treatment (panels: Control, Aquaperla, Stockosorb, Zeba) and algae density (lines: 22.8 × 103, 228 × 103, 2.228 × 106 cells/mL). RTE (0–1) denotes the probability that observations from a group exceed the pooled distribution (0 = mostly below, 1 = mostly above the pooled median).
Figure 12.
Weekly Relative Treatment Effects (RTEs) for the NPQI (chlorophyll-to-carotenoid index) across seven measurement weeks, stratified by SAP treatment (panels: Control, Aquaperla, Stockosorb, Zeba) and algae density (lines: 22.8 × 103, 228 × 103, 2.228 × 106 cells/mL). RTE (0–1) is the probability that observations from a group exceed the pooled distribution (0 = mostly below, 1 = mostly above the pooled median).
Figure 12.
Weekly Relative Treatment Effects (RTEs) for the NPQI (chlorophyll-to-carotenoid index) across seven measurement weeks, stratified by SAP treatment (panels: Control, Aquaperla, Stockosorb, Zeba) and algae density (lines: 22.8 × 103, 228 × 103, 2.228 × 106 cells/mL). RTE (0–1) is the probability that observations from a group exceed the pooled distribution (0 = mostly below, 1 = mostly above the pooled median).
Figure 13.
Principal component analysis score plot of raw absorbance spectra. Samples are plotted on PC1 (97.7% of variance) versus PC2 (1.4% of variance) axes, with each point colored and shaped according to its SAP treatment @ algal density. PC1 orders samples by biomass (lower densities on the left, higher on the right), while PC2 highlights subtler, treatment-specific spectral shifts.
Figure 13.
Principal component analysis score plot of raw absorbance spectra. Samples are plotted on PC1 (97.7% of variance) versus PC2 (1.4% of variance) axes, with each point colored and shaped according to its SAP treatment @ algal density. PC1 orders samples by biomass (lower densities on the left, higher on the right), while PC2 highlights subtler, treatment-specific spectral shifts.
Figure 14.
Loadings of the first two principal components from PCA of raw absorbance spectra (380–780 nm, 50 nm tick intervals). PC1 (red) exhibits strong positive loadings at chlorophyll-a absorption bands (~430–450 nm and ~670–680 nm), indicating that PC1 captures overall pigment concentration. PC2 (teal) displays negative loadings in the blue (≈450 nm) and red (≈680 nm) regions and positive loadings in the green–yellow region (≈525–600 nm), reflecting treatment-specific alterations in spectral shape.
Figure 14.
Loadings of the first two principal components from PCA of raw absorbance spectra (380–780 nm, 50 nm tick intervals). PC1 (red) exhibits strong positive loadings at chlorophyll-a absorption bands (~430–450 nm and ~670–680 nm), indicating that PC1 captures overall pigment concentration. PC2 (teal) displays negative loadings in the blue (≈450 nm) and red (≈680 nm) regions and positive loadings in the green–yellow region (≈525–600 nm), reflecting treatment-specific alterations in spectral shape.
Figure 15.
The mixed algae in the superabsorbent polymer (a); measurement of the spectral transmittance (b).
Figure 15.
The mixed algae in the superabsorbent polymer (a); measurement of the spectral transmittance (b).
Table 1.
ANOVA-Type Statistic (ATS) results for the effects of SAP treatment, algae density, and time on integrated absorbance.
Table 1.
ANOVA-Type Statistic (ATS) results for the effects of SAP treatment, algae density, and time on integrated absorbance.
| Effect | ATS | df | p |
|---|
| SAP | 91.38 | 2.34 | <0.001 |
| Algae | 456.76 | 1.81 | <0.001 |
| Time (Measurement) | 761.83 | 2.95 | <0.001 |
| SAP × Algae | 5.72 | 4.08 | <0.001 |
| SAP × Time | 20.22 | 5.55 | <0.001 |
| Algae × Time | 41.9 | 5.13 | <0.001 |
| SAP × Algae × Time | 12.95 | 8.26 | <0.001 |
Table 2.
Summary of Relative Treatment Effect (RTE) ranges for integrated absorbance across SAP treatments and algae densities.
Table 2.
Summary of Relative Treatment Effect (RTE) ranges for integrated absorbance across SAP treatments and algae densities.
| Treatment | Algae Density | M | SD | RTE Range |
|---|
| Control | 22.8 K | 0.4 | 0.4 | 0.02–0.84 |
| Control | 228 K | 0.6 | 0.4 | 0.10–0.94 |
| Control | 2228 K | 0.9 | 0.1 | 0.74–0.98 |
| Aquaperla | 22.8 K | 0.3 | 0.2 | 0.06–0.50 |
| Aquaperla | 228 K | 0.4 | 0.2 | 0.13–0.66 |
| Aquaperla | 2228 K | 0.6 | 0.1 | 0.36–0.67 |
| Stockosorb | 22.8 K | 0.2 | 0.2 | 0.03–0.43 |
| Stockosorb | 228 K | 0.3 | 0.2 | 0.11–0.56 |
| Stockosorb | 2228 K | 0.7 | 0.2 | 0.36–0.91 |
| Zeba | 22.8 K | 0.3 | 0.1 | 0.13–0.47 |
| Zeba | 228 K | 0.5 | 0.2 | 0.21–0.77 |
| Zeba | 2228 K | 0.8 | 0.1 | 0.52–0.87 |
Table 3.
ANOVA-Type Statistic (ATS) results for the effects of SAP treatment, algae density, and time on the chlorophyll index.
Table 3.
ANOVA-Type Statistic (ATS) results for the effects of SAP treatment, algae density, and time on the chlorophyll index.
| Effect | ATS | df | p |
|---|
| SAP | 310.3 | 2.87 | <0.001 |
| Algae | 1149.76 | 1.88 | <0.001 |
| Time (Measurement) | 1159.66 | 2.35 | <0.001 |
| SAP × Algae | 11.03 | 4.93 | <0.001 |
| SAP × Time | 21.57 | 4.43 | <0.001 |
| Algae × Time | 62.35 | 4.18 | <0.001 |
| SAP × Algae × Time | 17.19 | 6.63 | <0.001 |
Table 4.
Summary of Relative Treatment Effect (RTE) for the chlorophyll index across SAP treatments and algae densities.
Table 4.
Summary of Relative Treatment Effect (RTE) for the chlorophyll index across SAP treatments and algae densities.
| Treatment | Algae Density | M | SD | RTE Range |
|---|
| Control | 22.8 K | 0.5 | 0.4 | 0.07–0.89 |
| Control | 228 K | 0.6 | 0.3 | 0.20–0.96 |
| Control | 2228 K | 0.9 | 0.1 | 0.78–0.98 |
| Aquaperla | 22.8 K | 0.3 | 0.2 | 0.01–0.55 |
| Aquaperla | 228 K | 0.4 | 0.2 | 0.12–0.66 |
| Aquaperla | 2228 K | 0.6 | 0.1 | 0.39–0.73 |
| Stockosorb | 22.8 K | 0.2 | 0.2 | 0.03–0.44 |
| Stockosorb | 228 K | 0.4 | 0.2 | 0.11–0.60 |
| Stockosorb | 2228 K | 0.7 | 0.2 | 0.41–0.88 |
| Zeba | 22.8 K | 0.2 | 0.1 | 0.06–0.36 |
| Zeba | 228 K | 0.5 | 0.2 | 0.17–0.65 |
| Zeba | 2228 K | 0.7 | 0.1 | 0.46–0.82 |
Table 5.
ANOVA-Type Statistic (ATS) results for the effects of SAP treatment, algae density, and time on the blue/red ratio.
Table 5.
ANOVA-Type Statistic (ATS) results for the effects of SAP treatment, algae density, and time on the blue/red ratio.
| Effect | ATS | df | p |
|---|
| SAP | 195.56 | 2.48 | <0.001 |
| Algae | 41.93 | 1.72 | <0.001 |
| Time (Measurement) | 89.28 | 2.85 | <0.001 |
| SAP × Algae | 6.2 | 3.49 | <0.001 |
| SAP × Time | 6.07 | 4.47 | <0.001 |
| Algae × Time | 19.94 | 4.26 | <0.001 |
| SAP × Algae × Time | 2.99 | 6.06 | 0.006 |
Table 6.
Summary of Relative Treatment Effect (RTE) for the blue/red ratio across SAP treatments and algae densities.
Table 6.
Summary of Relative Treatment Effect (RTE) for the blue/red ratio across SAP treatments and algae densities.
| Treatment | Algae Density | M | SD | RTE Range |
|---|
| Control | 22.8 K | 0.5 | 0.3 | 0.05–0.92 |
| Control | 228 K | 0.4 | 0.3 | 0.08–0.79 |
| Control | 2228 K | 0.2 | 0.2 | 0.05–0.71 |
| Aquaperla | 22.8 K | 0.4 | 0.2 | 0.16–0.68 |
| Aquaperla | 228 K | 0.4 | 0.1 | 0.22–0.58 |
| Aquaperla | 2228 K | 0.4 | 0.2 | 0.23–0.66 |
| Stockosorb | 22.8 K | 0.5 | 0.2 | 0.28–0.73 |
| Stockosorb | 228 K | 0.5 | 0.2 | 0.18–0.70 |
| Stockosorb | 2228 K | 0.3 | 0.2 | 0.11–0.64 |
| Zeba | 22.8 K | 0.9 | 0 | 0.87–0.99 |
| Zeba | 228 K | 0.8 | 0.1 | 0.71–0.96 |
| Zeba | 2228 K | 0.7 | 0.1 | 0.52–0.84 |
Table 7.
ANOVA-Type Statistic (ATS) results for the effects of SAP treatment, algae density, and time on the normalized difference absorbance index.
Table 7.
ANOVA-Type Statistic (ATS) results for the effects of SAP treatment, algae density, and time on the normalized difference absorbance index.
| Effect | ATS | df | p |
|---|
| SAP | 47.23 | 1.58 | <0.001 |
| Algae | 66.07 | 1.5 | <0.001 |
| Time (Measurement) | 99.94 | 3.63 | <0.001 |
| SAP × Algae | 0.67 | 2.28 | 0.53 |
| SAP × Time | 3.39 | 4.95 | 0.005 |
| Algae × Time | 7.03 | 5.25 | <0.001 |
| SAP × Algae × Time | 1.64 | 6.58 | 0.124 |
Table 8.
Summary of Relative Treatment Effect (RTE) for the normalized difference absorbance index across SAP treatments and algae densities.
Table 8.
Summary of Relative Treatment Effect (RTE) for the normalized difference absorbance index across SAP treatments and algae densities.
| Treatment | Algae Density | M | SD | RTE Range |
|---|
| Control | 22.8 K | 0.4 | 0.4 | 0.08–0.89 |
| Control | 228 K | 0.3 | 0.3 | 0.04–0.72 |
| Control | 2228 K | 0.2 | 0.1 | 0.09–0.34 |
| Aquaperla | 22.8 K | 0.7 | 0.3 | 0.31–0.98 |
| Aquaperla | 228 K | 0.5 | 0.2 | 0.31–0.90 |
| Aquaperla | 2228 K | 0.4 | 0.1 | 0.16–0.53 |
| Stockosorb | 22.8 K | 0.7 | 0.2 | 0.44–0.96 |
| Stockosorb | 228 K | 0.5 | 0.2 | 0.32–0.89 |
| Stockosorb | 2228 K | 0.3 | 0.1 | 0.19–0.58 |
| Zeba | 22.8 K | 0.8 | 0.1 | 0.69–0.94 |
| Zeba | 228 K | 0.7 | 0.1 | 0.52–0.85 |
| Zeba | 2228 K | 0.5 | 0.1 | 0.36–0.60 |
Table 9.
ANOVA-Type Statistic (ATS) results for the effects of SAP treatment, algae density, and time on the Photochemical Reflectance Index.
Table 9.
ANOVA-Type Statistic (ATS) results for the effects of SAP treatment, algae density, and time on the Photochemical Reflectance Index.
| Effect | ATS | df | p |
|---|
| SAP | 120.57 | 2.75 | <0.001 |
| Algae | 43.24 | 1.69 | <0.001 |
| Time (Measurement) | 9.53 | 4.29 | <0.001 |
| SAP × Algae | 14.9 | 4.02 | <0.001 |
| SAP × Time | 3.69 | 6 | 0.001 |
| Algae × Time | 18.51 | 5.59 | <0.001 |
| SAP × Algae × Time | 3.84 | 6.67 | 0.000 |
Table 10.
Pairwise Wilcoxon rank-sum tests comparisons of absolute mean differences in average PRI across algae densities within each SAP treatment. Cells show the mean difference (row–column) and BH-adjusted significance (* p < 0.05; ns = not significant).
Table 10.
Pairwise Wilcoxon rank-sum tests comparisons of absolute mean differences in average PRI across algae densities within each SAP treatment. Cells show the mean difference (row–column) and BH-adjusted significance (* p < 0.05; ns = not significant).
| SAP | 22.8 × 103 vs. 228 × 103 | 22.8 × 103 vs. 228 × 103 | 228 × 103 vs. 2.228 × 106 |
|---|
| Control | 0.001 ns | 0.007 ns | 0.005 ns |
| Aquaperla | 0.079 ns | 0.061 ns | 0.018 ns |
| Stockosorb | 0.003 ns | 0.017 * | 0.014 * |
| Zeba | 0.011 ns | 0.018 ns | 0.007 ns |
Table 11.
ANOVA-Type Statistic (ATS) results for the effects of SAP treatment, algae density, and time on the Pigment Chlorophyll-to-Carotenoid Index.
Table 11.
ANOVA-Type Statistic (ATS) results for the effects of SAP treatment, algae density, and time on the Pigment Chlorophyll-to-Carotenoid Index.
| Effect | ATS | df | p |
|---|
| SAP | 133.37 | 2.35 | <0.001 |
| Algae | 113.14 | 1.76 | <0.001 |
| Time (Measurement) | 13.21 | 3.09 | <0.001 |
| SAP × Algae | 4.76 | 3.78 | 0.001 |
| SAP × Time | 2.37 | 6.48 | 0.023 |
| Algae × Time | 4.13 | 4.97 | 0.001 |
| SAP × Algae × Time | 1.89 | 8.7 | 0.05 |
Table 12.
Pairwise Wilcoxon rank-sum tests of absolute mean differences in average NPQI across algae densities within each SAP treatment. Cells show the mean difference (row–column) and BH-adjusted significance (* p < 0.05; ns = not significant).
Table 12.
Pairwise Wilcoxon rank-sum tests of absolute mean differences in average NPQI across algae densities within each SAP treatment. Cells show the mean difference (row–column) and BH-adjusted significance (* p < 0.05; ns = not significant).
| SAP | 22.8 × 103 vs. 228 × 103 | 22.8 × 103 vs. 228 × 103 | 228 × 103 vs. 2.228 × 106 |
|---|
| Control | 0.008 ns | 0.012 ns | 0.004 ns |
| Aquaperla | 0.023 ns | 0.070 * | 0.048 * |
| Stockosorb | 0.034 * | 0.059 * | 0.025 * |
| Zeba | 0.037 * | 0.072 * | 0.035 * |
Table 13.
Results of the Principal Component Analysis.
Table 13.
Results of the Principal Component Analysis.
| Component | Standard Deviation | Proportion of Variance (%) | Cumulative Variance (%) |
|---|
| PC1 | 1.416 | 97.70 | 97.70 |
| PC2 | 0.167 | 1.36 | 99.06 |
| PC3 | 0.115 | 0.65 | 99.71 |
| PC4 | 0.055 | 0.15 | 99.86 |
| PC5 | 0.031 | 0.05 | 99.91 |
Table 14.
Experimental setup of the Chlorella vulgaris–SAP growth study.
Table 14.
Experimental setup of the Chlorella vulgaris–SAP growth study.
| Treatment | SAP Type/Composition | Algal Density (Cells/mL) | pH | EC (ppm) | EC (mS cm−1) | Replicates | Volume per Replicate |
|---|
| Control | — (no SAP) | 22.8 × 103 | 7.0 | 391.75 | 0.7835 | 4 | 32 mL |
| Control | — (no SAP) | 228 × 103 | 7.0 | 386.25 | 0.7725 | 4 | 32 mL |
| Control | — (no SAP) | 2.228 × 106 | 8.0 | 389.25 | 0.7785 | 4 | 32 mL |
| Aquaperla | Potassium polyacrylate | 22.8 × 103 | 7.0 | 391.75 | 0.7835 | 4 | 32 mL |
| Aquaperla | Potassium polyacrylate | 228 × 103 | 7.0 | 386.25 | 0.7725 | 4 | 32 mL |
| Aquaperla | Potassium polyacrylate | 2.228 × 106 | 8.0 | 389.25 | 0.7785 | 4 | 32 mL |
| Zeba | Starch-g-poly(2-propenamide-co-2-propenoic acid) potassium salt | 22.8 × 103 | 7.0 | 391.75 | 0.7835 | 4 | 32 mL |
| Zeba | Starch-g-poly(2-propenamide-co-2-propenoic acid) potassium salt | 228 × 103 | 7.0 | 386.25 | 0.7725 | 4 | 32 mL |
| Zeba | Starch-g-poly(2-propenamide-co-2-propenoic acid) potassium salt | 2.228 × 106 | 8.0 | 389.25 | 0.7785 | 4 | 32 mL |
| Stockosorb | γ-polyglutamate | 22.8 × 103 | 7.0 | 391.75 | 0.7835 | 4 | 32 mL |
| Stockosorb | γ-polyglutamate | 228 × 103 | 7.0 | 386.25 | 0.7725 | 4 | 32 mL |
| Stockosorb | γ-polyglutamate | 2.228 × 106 | 8.0 | 389.25 | 0.7785 | 4 | 32 mL |